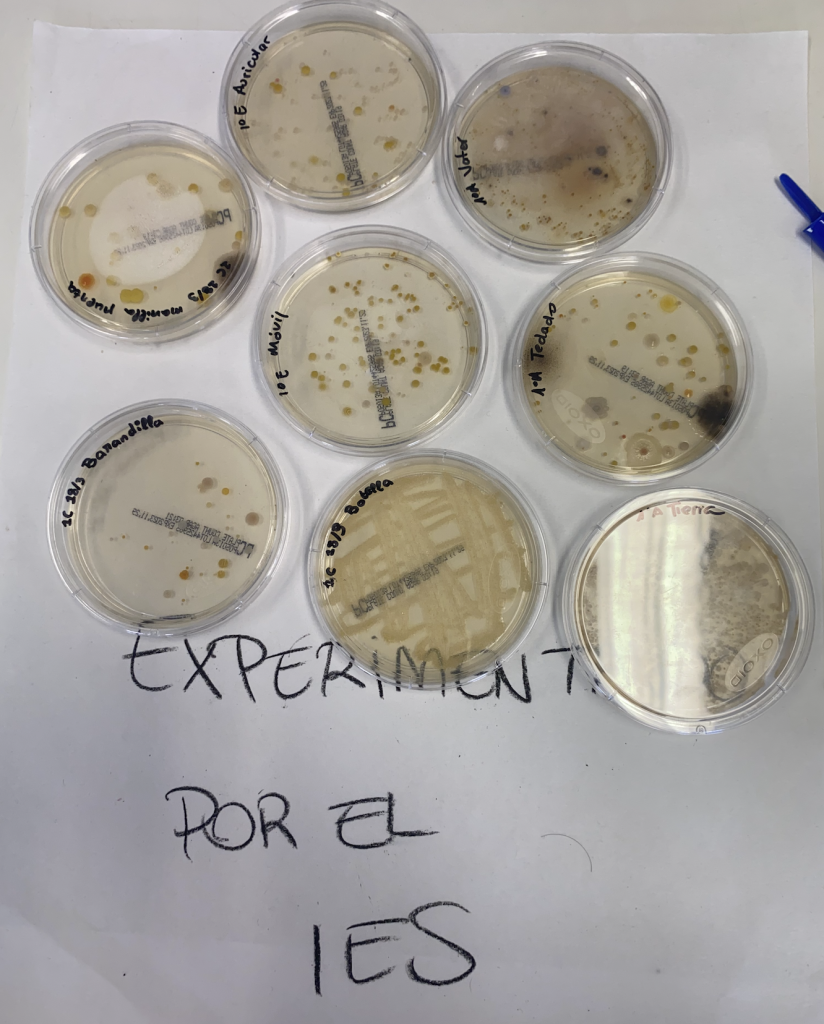
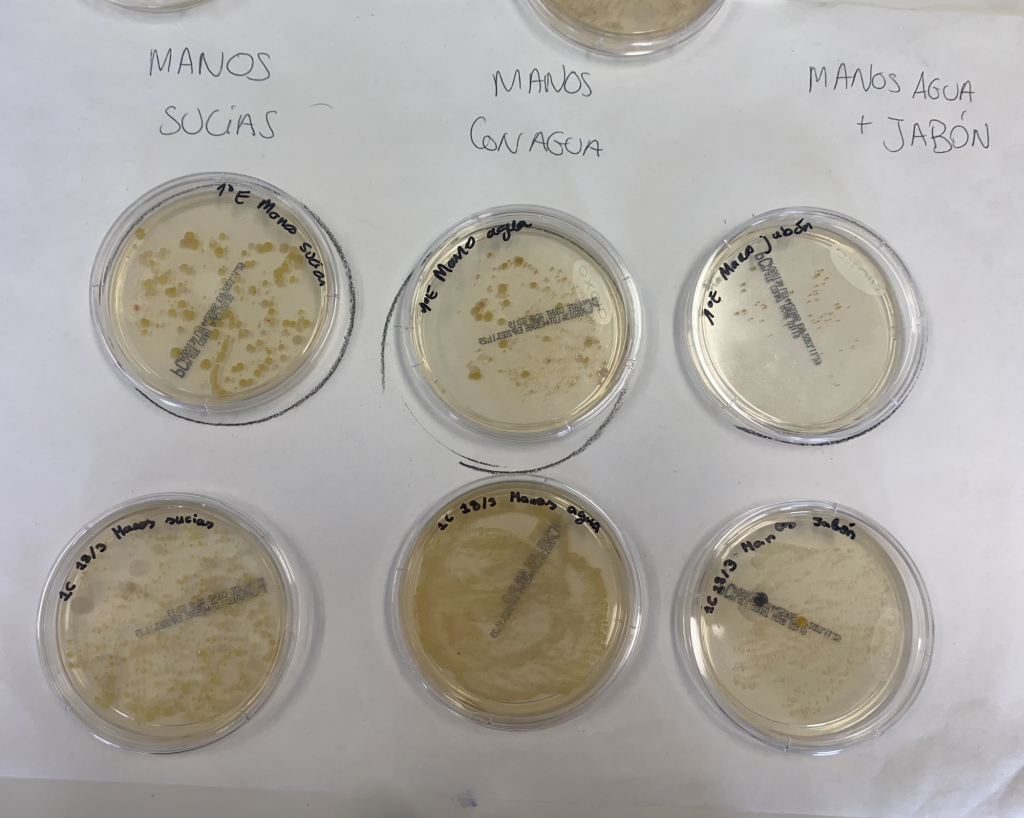

¿Y si tus alumnos pudieran descubrir bacterias, hongos, algas y protozoos reales… en una sola clase?
Esta propuesta convierte el laboratorio en una auténtica experiencia de exploración científica.
He diseñado una actividad en forma de estaciones de aprendizaje para 1º de ESO que permite al alumnado rotar por diferentes mesas, donde observarán, dibujarán, reflexionarán y experimentarán con microorganismos reales.
Todos los materiales están subidos a Kumumarket, pero en esta entrada te describo en detalle cada estación por si quieres llevarla al aula aunque no adquieras el material de apoyo.
🎯 Objetivos didácticos
- Observar distintos tipos de microorganismos reales: bacterias, hongos y protoctistas.
- Comprender la función ecológica y cotidiana de estos seres vivos.
- Familiarizarse con el uso del microscopio y el trabajo experimental.
- Desarrollar habilidades científicas: hipótesis, observación, registro y análisis.
- Fomentar la autonomía y el trabajo cooperativo mediante estaciones.
¿Cómo se lleva a cabo la práctica?
La clase se divide en grupos que irán rotando por 6 estaciones (más una estación final de evaluación/reflexión que es personal y opcional).
Cada estación explora un grupo de microorganismos a través de observación directa, experimentación sencilla y actividades adaptadas.
🕐 En cada estación dispondrán de 15-20 minutos para realizarla. Yo he tardado en hacer la práctica completa entre 2 y 3 días consecutivos.
📢 Cuando suene el cronómetro, el grupo debe cambiar de estación.
🧭 Estaciones de aprendizaje
🔎 Estación 1 – Las bacterias del yogur
Los alumnos observan bacterias teñidas de un yogur natural al microscopio.
Dibujan su forma, identifican el tipo y aprenden su función beneficiosa en el intestino a través de la investigación.
🧫 Estación 2 – Cultivando bacterias
Se comparan cultivos de bacterias tomados de manos (sucias, con agua, con jabón) y del entorno previamente sembradas en placas de Petri.
Reflexionan sobre la higiene y cómo se han formado las colonias bacterianas.

🍞 Estación 3 – El moho y la humedad
Observan alimentos con moho de diferentes tipos y usando el pan como sujeto de experimentación, se predice cómo crecerá en condiciones diferentes:
- Al aire libre
- En bolsa cerrada
- En bolsa cerrada con humedad
- Al aire libre seco
- Al aire libre con humedad
Además, completan un esquema sobre la estructura del moho: hifas, esporas y esporangios.



🍄 Estación 4 – Los hongos que forman setas
Analizan una seta real y sus esporas al microscopio.
Identifican las partes visibles (sombrero, laminillas, pie…) y comprenden su forma de reproducción a través de la liberación de esporas.



🎈 Estación 5 – El poder de las levaduras
Observan cómo un globo se infla gracias a la fermentación de levaduras.
(Se mezcla levadura, agua tibia y azúcar en un matraz y se coloca un globo en la boca del mismo).
Identifican alimentos que usan levaduras y dibujan el proceso de gemación observado al microscopio.


🌿 Estación 6 – La importancia de los protoctistas
A través de un “té de protozoos” cultivado en botella, observan organismos reales al microscopio.
Mediante dibujos y fotos reales de protozoos y algas unicelulares, y con ayuda de láminas de clasificación visual, aprenden a identificar este reino.
¡Importante! Veréis que en las láminas no he incluido el número de práctica en cada estación. Esto lo he hecho a propósito para que podáis alterar el orden, quitar estaciones si lo deseáis o reorganizarlas completamente a vuestro gusto, según las necesidades de vuestro grupo, el espacio disponible o los objetivos de la sesión.
Si compras las láminas y el cuaderno, podrás añadir de forma manual el número de estación en función del orden que hayas elegido.
📦 ¿Qué incluye el material completo?
➡️ En la versión que puedes descargar desde Kumumarket, encontrarás:
- ✅ El cuaderno del alumnado, con actividades guiadas y espacio para observaciones.
Es imprimible para trabajar directamente sobre él, o puedes usar una copia por grupo y que trabajen en sus libretas o «cuadernos de explorador». - ✅ Láminas visuales para cada estación, con diseño claro y llamativo para marcar el puesto de trabajo.
Incluye versión A4 (que también puedes imprimir en A3) lista para imprimir y plastificar. - ✅ Un pack de imágenes realistas para la identificación de protoctistas (estación 6), perfecto para complementar las observaciones al microscopio y una guía de identificación con dibujos.
- ✅ La guía del profesorado, con:
- Checklist de materiales para cada estación
- Recetas caseras para el cultivo de bacterias y protozoos
- Tips para organizar bien el espacio, el tiempo y los grupos

¿Quieres todo el material para descargar?
Puedes encontrar el recurso completo en Kumumarket:
🎒 Cuaderno + láminas + guía + ilustraciones científicas = todo listo para imprimir y aplicar.
🔗 Accede a la actividad completa en Kumumarket
¿Te animas a probarlo?
Si llevas esta práctica a clase o te inspira a montar tus propias estaciones, me encantará verlo.
📸 Etiquétame en Instagram @bioesosfera o cuéntamelo en los comentarios.
Y si necesitas adaptarlo a otro curso… ¡pregúntame!